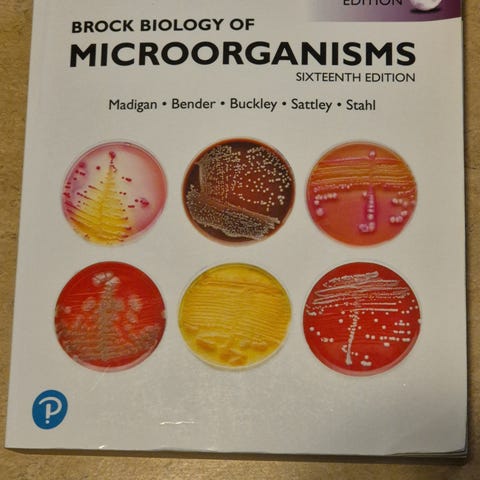

Bildegalleri
(1/1)
Farmasibok selges: Brock Biology of Microorganisms
Til salgs
Fiks ferdig
150 kr
Frakt fra 69 kr + Trygg betaling 39 kr
Trygg handel med Fiks ferdig
Varen sendes til deg, og du har 24 timer til å inspisere den før pengene overføres til selgeren.
Beskrivelse av varen
Brock Biology of Microorganisms: Global Edition
Av: Michael T. Madigan, David P. Clark, John M. Martinko, David A. Stahl
Forlag: Pearson Education (US)
ISBN: 9780321735515
Utgitt: 2011, Myk perm
Boken er lite brukt og i god stand/som ny. Kan møtes i Oslo eller omegn.
NB: Knappen for å vise hele beskrivelsen har kun en visuell effekt.
Brukerprofil

Du må være logget inn for å se brukerprofiler og sende meldinger.
Logg innAnnonsens metadata
Sist endret: 9.4.2026 kl. 09:56 ・ FINN-kode: 126518360
Utforsk våre nye sider for klær og mote
Ta en titt